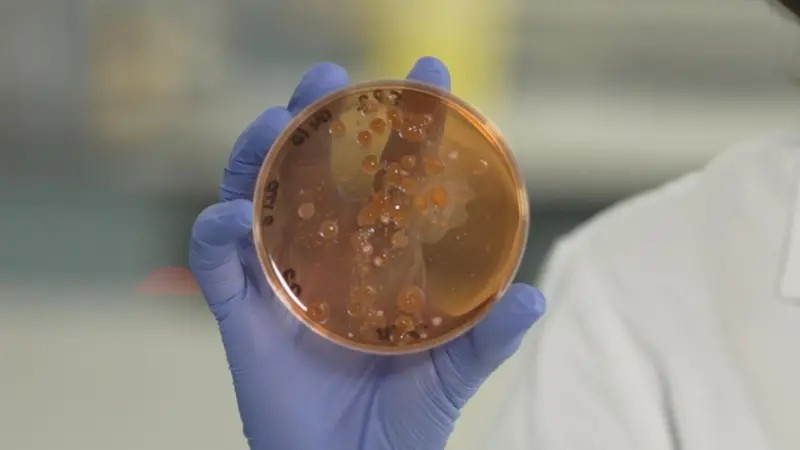

Та гоо сайхны бүтээгдэхүүнийхээ дуусах хугацааг мэдэх үү? Та өдөр бүр хэрэглэдэг гоо сайхны бүтээгдэхүүнийхээ дуусах хугацааг мэдэх үү? Анзаардаг уу?
Үнэндээ эмэгтэйчүүд үүнийг анзаардаггүй. Та хамгийн сүүлд хэзээ дуусах хугацааг нь хянасан бэ? Та багсаа хэд хоноод угаадаг вэ? Найзынхаа сормуусны будгаар будсан уу? Дэлгүүрийн уруулын будгийг туршсан юм биш биз? Таны цүнхэн дэх гоо сайхны бүтээгдэхүүнээс аль нь хамгийн их бактеритай вэ?
Эдгээр асуулт таны эрүүл мэндтэй холбоотой.
Лондоны метрополитан их сургуулийн эрдэмтэд эмэгтэйчүүдийн цүнхэн дэх гоо сайхны бүтээгдэхүүнийг микроскопоор шинжилжээ. Тэд хугацаа нь дууссан, нүдний харандаа, сормуусны будаг, уруул чийгшүүлэгч, уруулын будаг, нүүрний крем, багс, порлон зэргийг цуглуулсан аж. Тэдгээр бүтээгдэхүүнээс дээж авч, бактери үржүүлдэг саванд хийжээ.
Лондоны метрополитан их сургуулийн эрдэмтэд эмэгтэйчүүдийн цүнхэн дэх гоо сайхны бүтээгдэхүүнийг микроскопоор шинжилжээ. Тэд хугацаа нь дууссан, нүдний харандаа, сормуусны будаг, уруул чийгшүүлэгч, уруулын будаг, нүүрний крем, багс, порлон зэргийг цуглуулсан аж. Тэдгээр бүтээгдэхүүнээс дээж авч, бактери үржүүлдэг саванд хийжээ.
Ингэхэд нүдний харандаа хамгийн бохир байжээ. Нүдний харандааг сормуус, арьсандаа хүргэдэг. Иймд арьснаас стафилокок бактери амархан дамждаг байна.
Зарим эмэгтэйчүүд нүүрний будаг хэрэгслээ угаалгын өрөөндөө хадгалдаг. Энэ үеэр тэдгээр хэрэгсэл чийгтэй болж, бактери үржих таатай орчин бүрддэг байна.
Стафилокок бактери багс, порлон, сормуусны будгаас илэрчээ. Энэ бактери нүдийг цочроон, нүдний салст бүрхүүлийг үрэвсүүлэх (нүдний улаан ч гэдэг), арьсны гүний үрэвсэл гэх мэт халдварт өвчин үүсгэдэг. Иймд сормуусны будаг, нүдний харандааг хэрэглэсэн даруйдаа таглаж байгаарай.
Хэрэв таны арьс эрүүл бол хэдий бактеритай харандаа хэрэглэсэн ч улайхгүй, загатнахгүй. Харин арьсаа зүсэж гэмтээвэл эсвэл дархлаа султай бол аюултай.
Нүүрээ будахаасаа өмнө гараа угаана.
Бидний гар бохир байдаг тул гараас гоо сайхны хэрэгслүүдэд элдэв нян зөөвөрлөгдөж болзошгүй. Мөн заримдаа бүсгүйчүүд нүдээ хуруугаараа буддаг шүү дээ.
Гоо сайхны бүтээгдэхүүнийг шинжилсэн эрдэмтэд хүний гэдсэнд байдаг энтеробактери олжээ. Ариун цэвэр сахиагүй нөхцөлд эсвэл суултуурын усыг татах үед хүний ялгадаснаас гарч, усны дуслаар дамжин энэ бактери тархах боломжтой.
Суултуурын усыг татахад усны дуслууд хоёр метр хүртэл хол зайд хүрдэг байна. Мөн энтеробактери нь шээсний, амьсгалын замын, ясны чөмгийн халдвар, эндокардит хэмээх зүрхний өвчнийг үүсгэдэг.
Микроскопоор шинжлэх явцад гоо сайхны бүтээгдэхүүнээс кандида хэмээх мөөгөнцөр ч илэрчээ. Энэ нь хүний арьсыг нэвтлэн, амны хөндий, үтрээг өвчлүүлдэг.
Иймд та гоо сайхны бүтээгдэхүүнийхээ дуусах хугацааг шалгаарай. Тэдгээр бүтээгдэхүүнд хамгаалах үүрэгтэй нэмэлтүүд байдаг. Тэд хэдий болтол энэ үүргээ гүйцэтгэхийг савны ёроолд эсвэл таган дээр голдуу бичдэг.
Ус агуулсан бүтээгдэхүүнүүд бактери, мөөгөнцөрт илүү хурдан өртдөг тул цэвэр байлгах ёстой. Мөн нээснээс хойш ашиглах хугацаа ч чухал. Энэ нь бүтээгдэхүүн бүрд өөр өөр бөгөөд 3-12 сар хүртэл хугацаатай үйлдвэрлэдэг.
Хэрэв таны худалдаж авсан бүтээгдэхүүнд дуусах хугацаа заагаагүй бол та гурван сарын дараа хаяарай. Мөн худалдагч дуусах хугацааг тодорхой хэлж чадахгүй байвал худалдаж авахгүй байхыг зөвлөжээ.
Та энэ хүслийг өөр дээрээ нэмсэн байна!
Та энэ хүслийг биелүүлсэн байна!